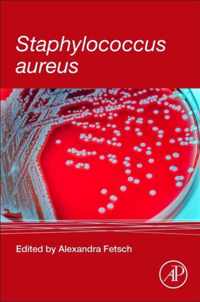
Staphylococcus aureus

modern techniques for pathogen detection online kopen
Ben je op zoek naar modern techniques for pathogen detection? Bekijk onze boeken selectie en zie direct bij welke webshop je modern techniques for pathogen detection online kan kopen. Ga je voor een ebook of paperback van modern techniques for pathogen detection. Zoek ook naar accesoires voor modern techniques for pathogen detection. Zo ben je er helemaal klaar voor. Ontdek ook andere producten en koop vandaag nog je modern techniques for pathogen detection met korting of in de aanbieding. Alles voor veel leesplezier!
Modern Techniques For Pathogen Detection
This outstanding overview sets a new standard for a methods book on pathogen detection. The first chapter provides an outline of currently;
Vergelijkbare producten zoals Modern Techniques For Pathogen Detection
Plant Pathogen Detection and Disease Diagnosis
This work provides information on the detection, identification, and differentiation of all microbial plant pathogens - presenting modern;
Vergelijkbare producten zoals Plant Pathogen Detection and Disease Diagnosis
Plant Pathogen Detection and Disease Diagnosis
This work provides information on the detection, identification, and differentiation of all microbial plant pathogens - presenting modern;
Vergelijkbare producten zoals Plant Pathogen Detection and Disease Diagnosis
Pathogen Detection Methods
Timely pathogen detection is an important issue for the efficient prevention of outbreaks in the populations world-wide. The development;
Vergelijkbare producten zoals Pathogen Detection Methods
Molecular Detection of Foodborne Pathogens
to be reported with alarming frequency. All-Encompassing Guide to Detection Techniques One of the most effective ways to control and;
Vergelijkbare producten zoals Molecular Detection of Foodborne Pathogens
Advances in Animal Disease Diagnosis
geographic areas * Describes the latest molecular assays for the rapid and accurate detection of pathogens * Helps in working towards meeting the;
Vergelijkbare producten zoals Advances in Animal Disease Diagnosis
Water Microbiology
in the populations world-wide. This book describes the direct detection of pathogens by molecular biologic techniques (ie: techniques based on;
Vergelijkbare producten zoals Water Microbiology
Fluorescent Probes
bacteriophages for bacteria detection, Probes used with point-of-care microfluidic devices for pathogen detection, Methods for combining FIB/SEM with;
Vergelijkbare producten zoals Fluorescent Probes
The Norovirus
The Norovirus: Features, Detection and Prevention of Foodborne Disease is a unique and valuable reference for both researchers;
Vergelijkbare producten zoals The Norovirus
Molecular Detection of Human Viral Pathogens
pathogens-including commercial kits-Molecular Detection of Human Viral Pathogens is an indispensable tool for medical, veterinary, and industrial;
Vergelijkbare producten zoals Molecular Detection of Human Viral Pathogens
Molecular Detection of Human Viral Pathogens
pathogens-including commercial kits-Molecular Detection of Human Viral Pathogens is an indispensable tool for medical, veterinary, and industrial;
Vergelijkbare producten zoals Molecular Detection of Human Viral Pathogens
Campylobacter
Campylobacter: Features, Prevention and Detection of Foodborne Disease is a unique and valuable reference for researchers in academics;
Vergelijkbare producten zoals Campylobacter
Soilborne Microbial Plant Pathogens and Disease Management, Volume One
detection of infection and precise identification, differentiation, and quantification of the microbial plant pathogens in plants, soil and water;
Vergelijkbare producten zoals Soilborne Microbial Plant Pathogens and Disease Management, Volume One
Soilborne Microbial Plant Pathogens and Disease Management, Volume One
: Presents techniques useful for detection, identification, quantification of microbial plant pathogens in plants, soil, and irrigation water from;
Vergelijkbare producten zoals Soilborne Microbial Plant Pathogens and Disease Management, Volume One
Methods in Microbiology
immunodiagnostic methods for the detection of pathogens have been comprehensively addressed. Most recent advancements on the role of Micro RNAs in silkworm;
Vergelijkbare producten zoals Methods in Microbiology
Existing and Potential Standoff Explosives Detection Techniques
Existing and Potential Standoff Explosives Detection Techniques examines the scientific techniques currently used as the basis for;
Vergelijkbare producten zoals Existing and Potential Standoff Explosives Detection Techniques
Staphylococcus aureus
applicability of those methods to other foodborne pathogens Covers the Staphylococcus aureus' mode of transmission, detection, biology and;
Vergelijkbare producten zoals Staphylococcus aureus
Emerging Trends in Nanotechnology
epitaxy. It also includes other interesting topics such as advancement in carbon nanotubes; processing techniques, purification and industrial;
Vergelijkbare producten zoals Emerging Trends in Nanotechnology
Microbial Foodborne Diseases
Through the use of molecular and cellular biological techniques, numerous advances have been made in understanding the molecular basis;
Vergelijkbare producten zoals Microbial Foodborne Diseases
Microbial Foodborne Diseases: Mechanisms of Pathogenesis and Toxin Synthesis
Through the use of molecular and cellular biological techniques, numerous advances have been made in understanding the molecular basis;
Vergelijkbare producten zoals Microbial Foodborne Diseases: Mechanisms of Pathogenesis and Toxin Synthesis
Detection and Analysis of SARS Coronavirus - Advanced Biosensors for Pandemic Viruses and Related Pathogens
: Advanced Biosensors for Pandemic Viruses and Related Pathogens expert chemists Chaudhery Mustansar Hussain and Sudheesh K. Shukla deliver a;
Vergelijkbare producten zoals Detection and Analysis of SARS Coronavirus - Advanced Biosensors for Pandemic Viruses and Related Pathogens
Biology of Foodborne Parasites
pathogen detection. It details individual foodborne protists and helminthes, with each chapter following a similar format for a consistent;
Vergelijkbare producten zoals Biology of Foodborne Parasites
Advances in Microbial Food Safety
with an interview with a food safety expert. Part two provides updates on single pathogens, and part three looks at pathogen detection;
Vergelijkbare producten zoals Advances in Microbial Food Safety
Veterinary Infection Biology
assays for veterinary use; molecular detection and identification of animal pathogens using a wide range of established techniques and covering;
Vergelijkbare producten zoals Veterinary Infection Biology
Modern Radar Detection Theory
Recently, various algorithms for radar signal detection that rely heavily upon complicated processing and/or antenna architectures have;
Vergelijkbare producten zoals Modern Radar Detection Theory
Plant-Pathogen Interactions
Plant-Pathogen Interactions: Methods and Protocols, Second Edition expands upon the first edition with current, detailed protocols for the;
Vergelijkbare producten zoals Plant-Pathogen Interactions
Detection and the Prevention of Leaks from Dams
The book describes in twelve chapters the modern tools available for the detection and prevention of leaks from dams and reservoirs;
Vergelijkbare producten zoals Detection and the Prevention of Leaks from Dams
Einde inhoud
Geen pagina's meer om te laden'